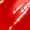
Fired Up, variant on Revlon ColorStay Satin Ink Long Lasting Lipstick with Vitamin E, On A Mission, 0.17 fl oz

Best seller
NYX Professional Makeup Lip Lingerie XXL Smooth Matte Liquid Lipstick, 16hr Longwear, Staying Juicy, 0.13 fl oz
NYX Professional Makeup Lip Lingerie XXL Smooth Matte Liquid Lipstick, 16hr Longwear, Staying Juicy, 0.13 fl ozNYX Professional Makeup Lip Lingerie XXL Smooth Matte Liquid Lipstick 16hr Longwear Staying Juicy 0 13 fl ozNYX Professional Makeup Lip Lingerie XXL Smooth Matte Liquid Lipstick 16hr Longwear Peach Flirt 0 13 fl ozNYX Professional Makeup Lip Lingerie XXL Matte Liquid Lipstick Hot CarameloNYX Professional Makeup Lip Lingerie XXL Smooth Matte Liquid Lipstick 16hr Longwear XXPose Me 0 13 fl ozNYX Professional Makeup Lip Lingerie XXL Liquid Lipstick Turn On 0 13 fl oz2 pack NYX Professional Makeup Lip Lingerie XXL Liquid Lipstick Sizzlin 0 13 fl ozNYX Professional Makeup Lip Lingerie XXL Smooth Matte Liquid Lipstick 16hr Longwear Straps Up 0 13 fl ozNYX Professional Makeup Lip Lingerie XXL Liquid Lipstick Unlaced 0 13 fl oz2 pack NYX Professional Makeup Lip Lingerie XXL Smooth Matte Liquid Lipstick 16hr Longwear Flaunt It 0 13 fl oz2 pack NYX Professional Makeup Lip Lingerie XXL Smooth Matte Liquid Lipstick 16hr Longwear Straps Up 0 13 fl oz4 pack NYX Professional Makeup Lip Lingerie XXL Matte Liquid Lipstick On Fuego2 pack NYX Professional Makeup Lip Lingerie XXL Matte Liquid Lipstick Naughty Noir2 pack NYX Professional Makeup Lip Lingerie XXL Smooth Matte Liquid Lipstick 16hr Longwear Deep Mesh 0 13 fl ozNYX Professional Makeup Lip Lingerie XXL Matte Liquid Lipstick On FuegoNYX Professional Makeup Lip Lingerie XXL Liquid Lipstick Stripd Down 0 13 fl ozNYX Professional Makeup Lip Lingerie XXL Smooth Matte Liquid Lipstick 16hr Longwear Pink Hit 0 13 fl oz2 pack NYX Professional Makeup Lip Lingerie XXL Liquid Lipstick Bust Ed 0 13 fl ozNYX Professional Makeup Lip Lingerie XXL Smooth Matte Liquid Lipstick 16hr Longwear Unhooked 0 13 fl oz2 pack NYX Professional Makeup Lip Lingerie XXL Matte Liquid Lipstick Goin Desnuda2 pack NYX Professional Makeup Lip Lingerie XXL Smooth Matte Liquid Lipstick 16hr Longwear XXPose Me 0 13 fl ozNYX Professional Makeup Lip Lingerie XXL Smooth Matte Liquid Lipstick 16hr Longwear Maxx Out 0 13 fl ozNYX Professional Makeup Lip Lingerie XXL Matte Liquid Lipstick Naughty NoirNYX Professional Makeup Lip Lingerie XXL Matte Liquid Lipstick Untamable2 pack NYX Professional Makeup Lip Lingerie XXL Matte Liquid Lipstick UntamableNYX Professional Makeup Lip Lingerie XXL Smooth Matte Liquid Lipstick 16hr Longwear Pushd Up 0 13 fl ozNYX Professional Makeup Lip Lingerie XXL Smooth Matte Liquid Lipstick 16hr Longwear It s Hotter 0 13 fl oz2 pack NYX Professional Makeup Lip Lingerie XXL Lightweight Long Lasting Matte Liquid Lipstick Knockout2 pack NYX Professional Makeup Lip Lingerie XXL Smooth Matte Liquid Lipstick 16hr Longwear It s Hotter 0 13 fl ozNYX Professional Makeup Lip Lingerie XXL Smooth Matte Liquid Lipstick 16hr Longwear Low Cut 0 13 fl oz2 pack NYX Professional Makeup Lip Lingerie XXL Liquid Lipstick Unlaced 0 13 fl oz2 pack NYX Professional Makeup Lip Lingerie XXL Matte Liquid Lipstick Hot CarameloNYX Professional Makeup Lip Lingerie XXL Matte Liquid Lipstick Goin Desnuda2 pack NYX Professional Makeup Lip Lingerie XXL Smooth Matte Liquid Lipstick 16hr Longwear Undressed 0 13 fl oz2 pack NYX Professional Makeup Lip Lingerie XXL Liquid Lipstick Stripd Down 0 13 fl ozNYX Professional Makeup Lip Lingerie XXL Liquid Lipstick Stamina 0 13 fl ozNYX Professional Makeup Lip Lingerie XXL Liquid Lipstick Bust Ed 0 13 fl oz2 pack NYX Professional Makeup Lip Lingerie XXL Smooth Matte Liquid Lipstick 16hr Longwear Peek Show 0 13 fl oz2 pack NYX Professional Makeup Lip Lingerie XXL Smooth Matte Liquid Lipstick 16hr Longwear Pushd Up 0 13 fl ozNYX Professional Makeup Lip Lingerie XXL Matte Liquid Lipstick Gettin CalienteNYX Professional Makeup Lip Lingerie XXL Smooth Matte Liquid Lipstick 16hr Longwear Flaunt It 0 13 fl ozNYX Professional Makeup Lip Lingerie XXL Liquid Lipstick Warm Up 0 13 fl oz2 pack NYX Professional Makeup Lip Lingerie XXL Smooth Matte Liquid Lipstick 16hr Longwear Maxx Out 0 13 fl oz2 pack NYX Professional Makeup Lip Lingerie XXL Smooth Matte Liquid Lipstick 16hr Longwear Staying Juicy 0 13 fl oz2 pack NYX Professional Makeup Lip Lingerie XXL Liquid Lipstick Stamina 0 13 fl oz2 pack NYX Professional Makeup Lip Lingerie XXL Matte Liquid Lipstick Candela BabeNYX Professional Makeup Lip Lingerie XXL Smooth Matte Liquid Lipstick 16hr Longwear Deep Mesh 0 13 fl oz2 pack NYX Professional Makeup Lip Lingerie XXL Matte Liquid Lipstick Gettin Caliente2 pack NYX Professional Makeup Lip Lingerie XXL Liquid Lipstick Warm Up 0 13 fl ozNYX Professional Makeup Lip Lingerie XXL Smooth Matte Liquid Lipstick 16hr Longwear Undressed 0 13 fl ozNYX Professional Makeup Lip Lingerie XXL Smooth Matte Liquid Lipstick 16hr Longwear Strip N Tease 0 13 fl oz2 pack NYX Professional Makeup Lip Lingerie XXL Smooth Matte Liquid Lipstick 16hr Longwear Pink Hit 0 13 fl ozNYX Professional Makeup Lip Lingerie XXL Liquid Lipstick XXTended 0 13 fl oz2 pack NYX Professional Makeup Lip Lingerie XXL Liquid Lipstick Turn On 0 13 fl ozNYX Professional Makeup Lip Lingerie XXL Liquid Lipstick Sizzlin 0 13 fl ozNYX Professional Makeup Lip Lingerie XXL Smooth Matte Liquid Lipstick 16hr Longwear Peek Show 0 13 fl ozNYX Professional Makeup Lip Lingerie XXL Matte Liquid Lipstick Candela Babe2 pack NYX Professional Makeup Lip Lingerie XXL Smooth Matte Liquid Lipstick 16hr Longwear Low Cut 0 13 fl ozNYX Professional Makeup Lip Lingerie XXL Lightweight Long Lasting Matte Liquid Lipstick Knockout2 pack NYX Professional Makeup Lip Lingerie XXL Smooth Matte Liquid Lipstick 16hr Longwear Strip N Tease 0 13 fl oz2 pack NYX Professional Makeup Lip Lingerie XXL Smooth Matte Liquid Lipstick 16hr Longwear Peach Flirt 0 13 fl oz
Actual Color:18 Stayin Juicy
Pack Size:Single
About this item
At a glance
- Makeup duration
- 16 hour
- Makeup shade
- Pink
- Ingredient preference
- Paraben-Free
- Ingredient properties
- Non-Irritating
- Features
- Long-Lasting
- Product line
- Lip Lingerie XXL
Current price is USD$10.97$84.39/fl oz
Price when purchased online
- Free 90-day returns
Subscribe, Your usuals, on your schedule, Save time and stay stocked!, $10.97
Your usuals, on your schedule
Save time and stay stocked!
One-time purchase $10.97
How do you want your item?
Plus, get 50% off an annual plan at checkout!
Sacramento, 95829
Arrives by Today
.Order within 9 hr 56 min
Sold and shipped by Walmart.com
This item is gift eligible
About this item
Frequently bought together

current price $10.97
$84.39/fl oz
NYX Professional Makeup Lip Lingerie XXL Smooth Matte Liquid Lipstick, 16hr Longwear, Staying Juicy, 0.13 fl oz
4.4 out of 5 Stars. 1401 reviews

current price $9.45
$9.45/count
NYX Professional Makeup Slim Lip Pencil, Long-lasting Creamy lip liner, Mahogany
4.4 out of 5 Stars. 1863 reviews

current price $17.91
$5.97/ea
(3 pack) NYX Professional Makeup Butter Gloss, Non-Sticky Lip Glosses, Sugar Glass (Clear), Stocking Stuffers 0.27 oz

current price $13.97
$49.89/oz
NYX Professional Makeup Wonder Stick Blush, Cream Blush Contour Stick, Coral Deep Peach
4.3 out of 5 Stars. 450 reviews
Current price is $52.30
Items may be delivered on different dates
Customer ratings & reviews
4.4 out of 5 stars
How item rating is calculated
Reviews summary
Pros
- : Product features a wide range of highly pigmented shades.
- : Has a non-drying, comfortable finish.
- : Allows for precise control due to unique applicator shape.
- : Has a vibrant color that suits various skin tones.
- : Offers a range of neutral and vibrant options to suit various skin tones.
Neutral
- : Can be quick, but may take a while and feel sticky.
Generated by AI
Customer images
- +413 images
Sort by |
Showing 1-3 of 893 reviews
Aug 23, 2025
WorldwideGirl
5 out of 5 stars review
Seller Verified Purchase
Not Budging
Review from NYX Professional Makeup
Helpful?
Oct 17, 2025
Angela
Top Reviewer
Item details
Color: FLAUNT IT
Multipack quantity: 1
5 out of 5 stars review
Verified Purchase
Stays on for days!
Helpful?
Jan 5, 2025
Constantine27
5 out of 5 stars review
Seller Verified Purchase
This is my all time reliable lipstick!
Review from NYX Professional Makeup
Helpful?